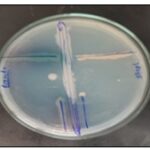
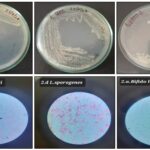

HARNESSING PROBIOTICS: GEL-BASED THERAPIES FOR DIABETIC WOUND HEALING
HTML Full TextHARNESSING PROBIOTICS: GEL-BASED THERAPIES FOR DIABETIC WOUND HEALING
Apurva Agharkar, Ankita Kelkar, Tushar Tapadiya, Gajanan Mali, Amol Muthal and Vaibhav Shinde *
Department of Pharmacognosy, Poona College of Pharmacy, Bharati Vidyapeeth (Deemed to be University), Pune, Maharashtra, India.
ABSTRACT: Diabetic wounds represent one of the most challenging complications of diabetes mellitus, characterized by impaired tissue regeneration, prolonged inflammation, and high susceptibility to infection. Conventional therapies often fail to achieve satisfactory healing outcomes, necessitating the exploration of novel strategies. Probiotics, with their antimicrobial, immunomodulatory, and regenerative properties, have emerged as promising candidates for wound care. This study investigated the therapeutic potential of three commercially available probiotic strains Bacillus clausii (Enterogermina®), Lactobacillus sporogenes (Sporlac®), and Bifidobacterium longum (Florachamp®) incorporated into a PEG–glycerol-based gel formulation for topical application. The developed gels were characterized for physicochemical stability, spreadability, pH, and viscosity, alongside confirmation of probiotic viability. In vitro assays revealed variable antagonistic activity against Staphylococcus aureus and Pseudomonas aeruginosa. Using a streptozotocin–nicotinamide-induced diabetic excision wound model in Wistar rats, the probiotic gels demonstrated significantly enhanced wound contraction, accelerated closure, and histological evidence of collagen deposition and re-epithelialization compared to diabetic controls. By Day 21, probiotic-treated groups exhibited healing efficacy comparable to the standard treatment (Placentrex® gel), with formulations containing Lactobacillus sporogenes and Bifidobacterium longum achieving >99% wound contraction. Translocation studies confirmed systemic presence of certain probiotic strains, suggesting possible systemic immunomodulatory contributions. These findings provide preliminary evidence that topical probiotic gels can effectively promote diabetic wound healing by modulating inflammation and enhancing tissue regeneration. Further clinical and mechanistic studies are warranted to optimize formulation parameters and establish safety profiles for translation into therapeutic practice.
Keywords: Probiotics, Diabetic wound healing, Topical gel formulation, Wound contraction, Tissue regeneration
INTRODUCTION: Diabetes is a long-term metabolic illness brought on by either the body's insufficient usage of insulin or the pancreas's insufficient production of insulin 1.
Diabetes mellitus is associated with a series of pathological alterations that significantly compromise the wound healing process.
Persistent hyperglycemia induces vascular dysfunction, leading to impaired perfusion and inadequate tissue oxygenation. Furthermore, diabetic patients commonly develop peripheral neuropathy and peripheral vascular disease, which not only delay the detection of wounds but also exacerbate their progression 2.
Foot ulcers are among the diabetic sores that affect up to 25% of the population with diabetes 3. Diabetic wound care alone consumes about a third of the total cost incurred in addressing diabetes and its complications 4. Diabetes-related wounds have a longer inflammatory phase of wound healing than non-diabetic wounds. This prolonged pro-inflammatory state can cause a chronic wound to form and hinders wound healing 5. Chronic wounds present major challenges for patients and healthcare providers, with diabetic foot infections being among the most debilitating complications. Current therapies are limited by adverse effects and insufficient healing outcomes, highlighting the need for alternative strategies. Bacteriotherapy, which employs beneficial microbes to counter pathogenic species, has gained attention as a promising approach in the era of rising antimicrobial resistance 6.
The skin microbiome comprises a diverse community of commensal bacteria, fungi, and viruses that inhabit the skin surface. It plays a crucial part in maintaining barrier integrity, modulating immune responses, and providing protection against pathogenic infections 7. The human microbiome plays a pivotal role in maintaining health and contributing to disease development. Microbial cells within the body outnumber host cells by a factor of ten, and their collective genetic material exceeds that of the host by an even greater margin. Advances in next-generation sequencing have revealed strong associations in the context of shifts in gut microbial composition and their contributory role in the development of autoimmune, metabolic, and atopic disorders 8, 9. Gut-skin axis refers to a newly recognized, bidirectional relationship wherein the gut microbiome can directly influence the composition and purpose of skin microbiome, and vice versa; both systems communicate through complex pathways involving microbial metabolites, immune mediators, and barrier functions, thereby impacting skin health and disease.
Probiotics are live microorganisms that help maintain or restore the gut microbiota, thereby promoting host health. Their expanding therapeutic relevance has positioned them as an innovative and rapidly evolving field of medical research 10. Probiotics confer a range of health benefits, including enhancement of immune function, stabilization of gut microbial ecology, suppression of pathogenic bacterial growth, and potential support for mental well-being 11, 12. Probiotics facilitate wound healing through multiple mechanisms, including modulation of immune responses, antimicrobial activity, and stimulation of tissue regeneration. Collectively, these functions contribute to the establishment of a microenvironment conducive to accelerated repair and recovery 13, 14.
In the present study, three commercially available probiotic formulations Enterogermina® (Bacillus clausii), Florachamp® (Bifidobacterium longum), and Sporlac® (Lactobacillus sporogenes) were selected to evaluate the strain-specific effects on diabetic wound healing. The gel formulation was designed to provide a favorable microenvironment that supports probiotic survival, incorporating an oil phase to enhance bacterial stability and maintain viable counts throughout application. Bacillus clausii, a rod-shaped, motile, spore-forming bacterium naturally present in the gastrointestinal tract and soil, is recognized as a probiotic species that coexists symbiotically with the host. It exhibits antimicrobial and immunomodulatory activities, partly attributed to the production of bacteriocin-like substances 15. Bifidobacterium longum, a rod-shaped, Gram-positive, catalase-negative member of the genus Bifidobacterium, is a commensal microorganism commonly residing in the human gastrointestinal tract 16. It has been reported to possess notable immunomodulatory and antioxidant properties, contributing to its therapeutic potential in maintaining host health and supporting disease management 17, 18. Lactobacillus sporogenes is a Gram-positive, spore-forming, motile, facultative anaerobic rod that has been reported to exert multiple therapeutic effects. It functions as a potent immunostimulant by enhancing T- and B-lymphocyte responsiveness, while also increasing plasma nitric oxide levels and significantly reducing malondialdehyde concentrations, thereby contributing to its antioxidant and immunomodulatory potential 19.
On this basis, the present study was designed to investigate the therapeutic potential of three commercially available probiotic strains Bacillus clausii, Bifidobacterium longum, and Lactobacillus sporogenes formulated into a topical gel for diabetic wound healing. The work aims to provide preliminary evidence supporting the use of probiotics as bioactive agents that promote tissue regeneration through modulation of inflammation, enhancement of collagen deposition, and improvement of re-epithelialization. The findings are intended to contribute to the development of probiotic-based wound care strategies, offering a safe, eco-sustainable, and potentially cost-effective alternative to conventional therapies, with broader implications for managing chronic and drug-resistant infections.
MATERIAL AND METHODS:
Materials: Commercial probiotic formulations Enterogermina®, Sporlac®, and Florachamp® were procured from a local pharmacy. These formulations contain the following probiotic strains: Enterogermina – Bacillus clausii, Sporlac Lactobacillus sporogenes, and Florachamp Bifidobacterium longum.
Culture media including de Man Rogosa agar (MRS), Muller Hinton agar (MHA), Bifidobacterium agar (BA), and Nutrient agar were obtained from HiMedia Laboratories Pvt. Ltd., Mumbai, India. Chemical reagents such as glycerol, polyethylene glycol 400 (PEG 400), and polyethylene glycol 4000 (PEG 4000) were sourced from Loba Chemie Pvt. Ltd., Mumbai, India. Streptozotocin was purchased from Sigma-Aldrich, USA, and nicotinamide from SRL Chemicals, India. Placentrex gel was used as the standard teatment control.
Bacterial Growth: The selected probiotic formulations Enterogermina® (Bacillus clausii), Sporlac® (Lactobacillus sporogenes), and Florachamp® (Bifidobacterium longum) were initially suspended in peptone water to facilitate microbial dispersion. Each formulation was then inoculated onto its respective selective agar medium based on strain compatibility and literature precedence: Bacillus clausii on Muller Hinton Agar (MHA), Lactobacillus sporogenes on Nutrient Agar, and Bifidobacterium longum on de Man Rogosa Sharpe (MRS) Agar. The plates were incubated under appropriate conditions to promote optimal bacterial growth and viability assessment.
In-vitro Antagonistic Activity: Staphylococcus aureus and Pseudomonas aeruginosa are among the most prevalent pathogens associated with diabetic wounds. To assess the antagonistic potential of the selected probiotic strains (Bacillus clausii, Lactobacillus sporogenes, and Bifidobacterium longum), the giant-colony technique was employed. In this method, the probiotic strain was streaked along the central axis of the agar plate, while the pathogenic strain was inoculated perpendicularly. The degree of inhibition at the intersection was used as an indicator of antagonistic activity, thereby evaluating the sensitivity of each pathogenic species to the probiotic strains.
Formulation of Gel: The gel formulations were prepared following the method reported by Farkhonde Karimi et al., with slight modifications 20. Polyethylene glycol (PEG) 400 and PEG 4000 were used as gelling agents, while glycerol served as the oil phase to enhance probiotic stability. All procedures were conducted under aseptic conditions to minimize microbial contamination. Briefly, PEG 400 was gently heated and dissolved in PEG 4000 with continuous moderate stirring until a clear base was obtained. Glycerol was then gradually incorporated into the mixture under constant stirring to ensure homogeneity. Finally, the selected probiotic strains were incorporated into the gel base with continuous mixing to achieve uniform distribution. For optimization, three batches (F1, F2, and F3) were with varying excipient concentrations, as detailed in Table 1, which outlines the composition of each probiotic gel formulation.
TABLE 1: COMPOSITION OF PROBIOTIC GEL FORMULATIONS
| Ingredients | F1 | F2 | F3 |
| Glycerol(%w/v) | 21 | 23.07 | 25.14 |
| PEG 400(%w/v) | 21 | 23.07 | 25.14 |
| PEG 4000(%w/v) | 1.5 | 3.85 | 5.65 |
| API (Probiotic bacteria) | Marketed formulation | Marketed formulation | Marketed formulation |
Note: F1 = Gel base + Enterogermina® suspension (5 mL ≈ 2 billion spores), F2 = Gel base + Sporlac® powder (1 g ≈ 150 million spores), F3= Gel base + Florachamp® powder (5 g ≈ 5 billion cells).
Characterization of Gel Formulations:
Physical Features and Clarity: The visual clarity and appearance of the formulated probiotic gels were assessed against both black and white backgrounds under ambient lighting conditions. Observations were recorded for transparency, homogeneity, and presence of particulate matter.
pH Determination: The pH of each gel sample was evaluated using a digitally calibrated pH meter. For accuracy, three independent readings were taken per sample, and the average value was reported.
Spreadability Test: Spreadability was evaluated by placing 0.5 g of gel within a 2 cm diameter circle on a clean glass plate. A second glass plate was gently placed on top, followed by a 500 g weight applied for 5 minutes. The final diameter of the spread gel was measured to assess ease of application and uniformity.
Centrifugation Stability: To assess physical stability, 5 g of each gel formulation was transferred into a tapered-end test tube and subjected to centrifugation at 5,000 rpm for 20 minutes at room temperature using a Remi Medico Centrifuge (Model C-852). Post-centrifugation, samples were examined for phase separation or sedimentation.
Viscosity Measurement: Viscosity was determined using a Brookfield Viscometer (Model RVDV-E). Each gel sample was rotated at incremental speeds of 10, 20, 30, 40, 50, and 60 rpm. Dial readings were recorded at each speed, and viscosity profiles were plotted to evaluate rheological behaviour.
Stability Studies: Accelerated stability testing of the probiotic gel formulations was conducted in accordance with ICH guidelines (Q1A (R2)). Each gel was stored in collapsible tubes under ambient (20°C–25°C) and accelerated (40°C ± 2°C) conditions for 12 days, with periodic evaluation of clarity, pH, and consistency to assess physical and chemical stability 21. The results were used to project the shelf-life and robustness of the gel matrix under simulated storage conditions.
Probiotic Growth and Identity: To confirm the viability and identity of probiotic strains within the gel formulations, samples were streaked onto selective agar plates using the streak plate method and incubated for 24 hours under appropriate conditions. Post-incubation, bacterial colonies were examined for morphological characteristics. Gram staining was performed by transferring the cultured bacteria onto glass slides, followed by microscopic evaluation to determine cell shape, Gram reaction, and structural features consistent with the respective probiotic strains.
In-vivo Evaluation:
Ethical Standards: Male Wistar rats (180–250 g) were procured from Global BioResearch Solutions Pvt. Ltd., Pune, India. The animals were acclimatized for one week under standard laboratory conditions prior to experimentation. All experimental procedures were approved by the Institutional Animal Ethics Committee (IAEC), Poona College of Pharmacy, Bharati Vidyapeeth (Deemed University), Pune, India, under protocol number PCP/IAEC/2024/2-30, and were conducted in accordance with CPCSEA guidelines.
Animals and Experimental Design: Experimental animals were maintained in polypropylene cages under standardized environmental conditions (temperature: 22–25 °C; relative humidity: 30–70%; 12-hour light/dark cycle). All subjects had unrestricted access to a standard pellet diet and water. A total of 36 rats were randomly allocated into six groups, with six animals per group (n = 6).
Group I (Normal Control): Non-diabetic, untreated.
Group II (Disease Control): Diabetic, untreated.
Group III (Standard): Diabetic, treated with Placentrex® gel.
Group IV (F1): Diabetic, treated with probiotic gel containing Bacillus clausii.
Group V (F2): Diabetic, treated with probiotic gel containing Lactobacillus sporogenes.
Group VI (F3): Diabetic, treated with probiotic gel containing Bifidobacterium longum.
Diabetes Induction: Type 2 Diabetes Mellitus was experimentally induced in overnight-fasted Wistar rats through a single intraperitoneal administration of nicotinamide (120 mg/kg), followed 15 minutes later by streptozotocin (45 mg/kg), freshly dissolved in 0.1 M cold citrate buffer (pH 4.5). Post-injection, animals were rested for six hours and subsequently provided with 5% glucose solution ad libitum for 24 hours to mitigate hypoglycemia-related mortality. After 72 hours, fasting blood glucose levels were recorded, and rats exhibiting values exceeding 215 mg/dL were classified as diabetic and enrolled in the experimental protocol.
Excision Wound Model: The excision wound model was developed in accordance with the methodology outlined by U. Anushree et al 22. In brief, the dorsal skin of each rat was cleansed and depilated using ethanol to prepare the site for wound induction. Under anaesthesia, a circular area of 2 cm diameter was marked using a sterile marker 23. A full-thickness excision was performed, removing the skin down to the muscle layer. Post-surgery, each animal was housed individually to prevent interference with wound healing.
Evaluation of Wound Healing: Topical application of gel formulations and standard treatments began on Day 1 and continued twice daily until Day 21. Wound healing was assessed by monitoring the reduction in wound size at regular intervals. The extent of wound contraction was compared across treatment groups based on the change in wound area relative to the initial size 24.
Translocation Studies: To assess microbial translocation, blood samples were collected from the retro-orbital plexus of probiotic-treated rats at the end of the study. Samples were drawn into sterile EDTA-coated tubes and immediately spread onto selective agar media: deMan Rogosa Sharpe (MRS) agar, Bifidobacterium agar, and Mueller-Hinton agar. Plates were incubated at 37°C for 48 hours, and microbial growth was monitored to evaluate systemic translocation of probiotic strains 25.
Histopathology Studies: Excised wound tissues were fixed in 4% buffered formalin and embedded in paraffin wax following standard histological protocols. After sectioning at 5 μm thickness, samples were stained with hematoxylin and eosin (H&E). Microscopic evaluation was performed under 100× magnification to assess histological changes, including epithelialization, collagen deposition, inflammatory cell infiltration, and neovascularisation 26.
Statistical Analysis: All data were expressed as Mean ± SEM. Statistical comparisons were conducted using GraphPad Prism 9.0 software. Group differences were analyzed by two-way ANOVA, followed by Bonferroni’s post hoc test to determine significance across treatment groups. A p-value less than 0.05 was considered statistically significant.
RESULTS:
In-vitro Antagonistic Activity: The antagonistic potential of selected probiotic strains was evaluated against Pseudomonas aeruginosa and Staphylococcus aureus. Bacillus clausii exhibited resistance to Pseudomonas aeruginosa, while showing slight sensitivity to Staphylococcus aureus. In contrast, Lactobacillus sporogenes demonstrated notable inhibitory activity against Staphylococcus aureus, but showed limited effectiveness against Pseudomonas aeruginosa. Bifidobacterium longum displayed no observable antagonistic effect against Pseudomonas aeruginosa, though it exhibited mild activity against Staphylococcus aureus. These findings are illustrated in Fig. 1, which depicts the comparative antagonistic profiles of the tested probiotic strains.
FIG. 1: IN-VITRO ANTAGONISTIC ACTIVITY
Probiotics Growth and Viability: The developed gel-based probiotic formulations demonstrated satisfactory microbial growth and preserved morphological integrity upon incorporation into the gelling matrix. Gram staining of the cultured bacteria confirmed characteristic features of the respective probiotic strains. Lactobacillus sporogenes exhibited a Gram-positive reaction with a bacillus-shaped morphology, while Bacillus clausii also showed Gram-positive staining and a rod-like structure. Similarly, Bifidobacterium longum displayed Gram-positive staining with a rod-shaped appearance, consistent with its known probiotic identity show in Fig. 2.
FIG. 2: PROBIOTICS GROWTH AND MORPHOLOGY
General Characterization: The developed gelling systems were evaluated using a set of macroscopic parameters, with results summarized in Table 2. The formulations exhibited visual characteristics ranging from milky white to moderately cloudy, indicating uniform dispersion and acceptable clarity across batches. Upon incorporation of marketed probiotic formulations into the gel base, Formulations F1 and F2 retained their original appearance with no observable color change, suggesting compatibility with the gelling matrix. In contrast, Formulation F3 displayed a slight orange tint, attributed to specific constituents present in the commercial product.
TABLE 2: GENERAL CHARACTERIZATION OF PROBIOTIC GEL FORMULATIONS
| Sr. no. | Characterization parameter | F1 | F2 | F3 |
| 1 | Appearance | Translucent | Milky | Translucent |
| 2 | Texture | Slightly rough | Smooth | Rough |
| 3 | pH | 5.2 | 5.1 | 5.0 |
| 4 | Viscosity (CP) | 874 | 1125 | 507 |
| 5 | Spreadability (cm) | + | +++ | ++ |
| 6 | Centrifugation | Visual instability | Visually stable | Visual instability |
In-vivo Study:
Effect of Probiotics on Wound Area and % Wound Contraction: During the 24-day study period, rats treated with probiotic gel formulations, conventional Placentrex® gel, and untreated controls exhibited broadly similar wound healing trajectories, with notable differences in the rate and extent of contraction. The study evaluated two key parameters: wound size reduction in millimeters and percentage contraction relative to the initial wound area. Diabetic control rats (Group II) showed a significantly slower healing response compared to normal controls (Group I), confirming the impaired wound resolution typically associated with diabetic conditions. By Day 14, probiotic gel-treated rats began showing accelerated wound closure. By Day 21, the wound contraction percentages were as follows: Group I (Normal Control) showed 99.23% contraction, while Group II (Diabetic Control) exhibited only 80.08%. Among the probiotic-treated groups, Group III (F1) achieved 98.87% contraction, and both Group IV (F2) and Group V (F3) reached 99.56%. The contraction percentage for Group VI (standard treatment with Placentrex® gel) was 99.57%. These results underscore the curative capacity of probiotic gels in enhancing wound healing under diabetic situations, with efficacy approaching that of normal wound physiology. Fig. 3 supports these findings by visually depicting the wound contraction trends across all groups.
FIG. 3: VISUAL PROGRESSION OF WOUND HEALING ACROSS TREATMENT GROUPS OVER 24 DAYS
Wound Area Reduction (mm): The wound healing efficacy of the developed probiotic gel formulations was assessed by monitoring the progressive reduction in wound area over a 24-day period, as detailed in Table 3.
Measurements were recorded in millimeters and expressed as mean ± SEM (n = 4), with statistical analysis performed using two-way ANOVA followed by Bonferroni multiple comparison test. At Day 0, all experimental groups exhibited comparable wound sizes (~19–20 mm), ensuring a uniform baseline. The normal control (NC) group demonstrated steady wound contraction, culminating in a minimal wound area of 1.92 ± 0.3 mm by Day 24.
In contrast, the diabetic control (DC) group showed significantly delayed healing, retaining a wound size of 9.15 ± 0.02 mm at the study’s end. Notably, probiotic-treated groups (F1, F2, F3) and the standard treatment group (Std) exhibited markedly improved healing outcomes relative to DC. Among these, F2 and F3 achieved near-complete wound closure (1.2 ± 0.2 mm and 1.22 ± 0.3 mm, respectively), comparable to NC. Statistical significance was denoted as follows: *p < 0.001 vs. DC; ##p < 0.01 vs. NC.
TABLE 3: PROGRESSIVE WOUND AREA REDUCTION OVER 24 DAYS
| Day 0 | Day 4 | Day 7 | Day 10 | Day 14 | Day 18 | Day 21 | Day 24 | |
| NC | 19.75±0.3 | 18.62±0.2 | 16.2±0.4 | 14.62±0.3 | 11.2±0.5 | 7.62±0.2 | 3.57±0.2 | 1.92±0.3 |
| DC | 19.7±0.2 | 18.55±0.2 | 18.02±0.3 | 16.45±0.1 | 14.57±0.3 | 12.87±0.3 | 11±0.3### | 9.15±0.02 |
| Std | 19.1±0.5 | 17.65±0.2 | 15.7±0.3 | 13.6±0.3** | 11.02±0.3** | 8.95±0.2*** | 5.07±0.3*** | 1.32±0.3*** |
| F1 | 19.6±0.2 | 17.35±0.7 | 15.75±0.5 | 12.87±1.0 | 11.5±0.4 | 8.87±0.0.4** | 5.6±0.4*** | 2.27±0.4*** |
| F2 | 19.5±0.3 | 17.07±0.1 | 16.47±0.2 | 15.2±0.3 | 12.8±0.3 | 8.92±0.3*** | 2.67±0.3*** | 1.2±0.2*** |
| F3 | 19.75±0.3 | 19.12±0.4 | 17.77±0.3 | 16.72±0.3 | 12.77±0.2 | 8.67±0.3*** | 3.82± 0.3*** | 1.22±0.3** |
Percentage Wound Contraction: The percentage wound contraction over a 24-day period was evaluated for all experimental groups, with results presented in Table 4. Data are expressed as mean ± SEM (n = 4) and analyzed using two-way ANOVA followed by Bonferroni post hoc test. At Day 0, all groups began with comparable wound sizes, ensuring a consistent baseline. The normal control (NC) group exhibited rapid and progressive healing, achieving 99.24 ± 3.11% contraction by Day 24. In contrast, the diabetic control (DC) group showed significantly impaired healing, with only 80.08 ± 3.14% contraction at the same time point. Treatment with probiotic formulations F1, F2, and F3 resulted in enhanced wound contraction compared to DC, with F2 and F3 reaching 99.56 ± 0.05%, closely mirroring the NC group. The standard treatment (Std) also demonstrated strong efficacy, achieving 99.57 ± 0.12% contraction. These outcomes demonstrate the significant wound-healing efficacy of probiotic gel formulations, with pronounced effects observed in diabetic models. Statistical comparisons were expressed as follows: p < 0.001 vs. diabetic control (DC); ##p < 0.01 vs. normal control (NC).
TABLE 4: PERCENTAGE WOUND CONTRACTION OVER 24 DAYS
| Day 0 | Day 4 | Day 7 | Day 10 | Day 14 | Day 18 | Day 21 | Day 24 | |
| NC | 2.44±0.00 | 16.69±0.58 | 37.94±2.60
|
50.88±2.45
|
70.81±3.18 | 86.27±4.14
|
96.93±2.78
|
99.24±3.11 |
| DC | 4.88±1.37 | 19±1.41
|
23.38±3.07
|
36±3.82
|
49.19±3.62 | 62.44±3.18
|
79.88±2.51## | 80.08±3.14 |
| Std | 11.94±1.13 | 27.75±0.99 | 39.88±0.48** | 57.63±1.14*** | 72.38±0.33*** | 80.92±0.24*** | 94.31±0.29*** | 99.57±0.12*** |
| F1 | 4.88±0.36 | 27.38±0.60 | 39.75±0.93
|
60.38±3.31* | 69.63±1.59* | 81.88±0.31*** | 93.06±0.85*** | 98.88±0.18*** |
| F2 | 5.87±0.73 | 29.60±3.32 | 37.94±2.15
|
45.56±2.02
|
62.44±0.39 | 81.88±0.27*** | 98.38±0.29*** | 99.56±0.05*** |
| F3 | 2.44±1.64 | 12.06±1.55* | 25.56±0.55 | 33.94±0.52
** |
60.88±0.74 | 81.88±0.53
*** |
96.88±0.25
*** |
99.56±0.05*** |
Histopathology Study: Histopathological examination revealed distinct differences in wound healing progression across experimental groups. In the diabetic control group, which received no treatment, tissue sections showed marked infiltration of inflammatory cells, neovascularization, and granulation tissue formation. However, re-epithelialization remained incomplete even by Day 21, indicating delayed wound resolution. By Day 7, animals treated with the standard Placentrex® gel exhibited early signs of healing, characterized by the proliferation of granulation tissue composed of fibrous connective elements and initial collagen deposition. Probiotic-treated groups also demonstrated early collagen deposition at the wound site, suggesting active tissue remodeling during the initial phase of healing. On Day 14, a noticeable reduction in inflammatory cell presence was observed in both the standard and probiotic-treated groups, accompanied by clear evidence of re-epithelialization. By Day 21, complete wound closure was evident in these groups, with restoration of the epidermal layer, dense collagen deposition in the dermis and subcutaneous tissue, and minimal to negligible inflammatory infiltration indicating successful tissue regeneration and resolution of inflammation, as illustrated in Fig. 4.
FIG. 4: HISTOLOGICAL EVALUATION OF TISSUE REGENERATION ACROSS TREATMENT GROUPS AT DAYS 7, 14, AND 21
DISCUSSION: The therapeutic use of probiotics dates back to ancient times, with various traditional medical systems harnessing beneficial bacteria to treat a wide range of ailments. While oral probiotic therapy has demonstrated systemic immuno-modulatory effects, its ability to directly influence the skin microbiota remains limited. In contrast, topical application of probiotics offers distinct dermatological advantages. These include the biosynthesis of ceramides, enhanced skin hydration and elasticity, and reduction in erythema, scaling, and irritation. Topical probiotics also play a pivotal role in the remodelling of dermal and epidermal tissues and can exert direct anti-inflammatory effects. Local probiotic administration further contributes to skin health by inhibiting pathogenic colonization and modulating host immune responses. Mechanistically, this is achieved through the production of bacteriocins, competitive inhibition of biofilm formation and microbial adhesion, restoration of the skin’s acidic pH, and stimulation of mucin production. These multifaceted actions underscore the dynamic interplay between the skin microbiome and its environment, opening new avenues for dermatological research and therapeutic innovation. Moreover, the interdependence between gut flora and skin homeostasis suggests that maintaining a balanced microbiome may be critical in managing infections and chronic skin disorders. Consequently, the natural remedies sector particularly in the domains of probiotics and postbiotics has garnered increasing interest from both pharmaceutical and cosmetic industries, signaling a paradigm shift toward microbiome-centered skin therapies 27.
Topical probiotics, first proposed in 1912 for treating acne and seborrhea, function by delivering live, lab-cultured bacteria to the skin to restore microbiota balance and immunological homeostasis. Unlike oral probiotics, topical formulations directly interact with skin commensals, inducing antimicrobial peptides (AMPs) from keratinocytes and sebocytes that suppress pathogenic bacteria. These interactions foster microbial synergy and enhance cutaneous defense mechanisms. Probiotics contribute to wound healing by inhibiting pathogen adhesion, preventing biofilm formation, and modulating inflammatory responses. Though the molecular pathways remain partially understood, they are known to influence key mediators such as cytokines, chemokines, and growth factors. Notably, probiotics reduce bacterial load, neutrophil infiltration, and cell apoptosis, while promoting keratinocyte migration and upregulating genes like TGF-β1, FGF7, VEGF-A, and IL-8 collectively accelerating tissue regeneration and repair. Probiotics have demonstrated promising effects across various biomedical applications, particularly in wound regeneration. Multiple formulations such as probiotic suspensions, precipitates, cell-free supernatants, and postbiotics have been employed to enhance healing outcomes. Postbiotics, in particular, play a key role by boosting hydroxyproline levels and promoting collagen deposition, thereby accelerating tissue repair and regeneration 28, 29.
Probiotic therapy has emerged as a promising strategy for addressing chronic wounds and mitigating antibiotic resistance both of which pose significant global health challenges. In experimental models, topical administration of probiotics has been shown to markedly accelerate wound healing, with different microbial strains exhibiting optimal efficacy at distinct stages of recovery. The wound healing process is a complex, multicellular cascade that unfolds in sequential phases: inflammation, proliferation, re-epithelialization, and haemostasis. These phases are commonly assessed through a combination of histological, biochemical, and biomarker-based parameters 30.
Each phase is orchestrated by a dynamic interplay of physical, biochemical, and cellular factors. Among these, fibroblasts play a pivotal roleespecially during the proliferative phaseby contributing to extracellular matrix (ECM) remodelling and tissue regeneration. Vascular endothelial growth factor (VEGF) is a key mediator in this process, driving angiogenesis, epithelialization, and collagen synthesis. Collagen, a major ECM component, facilitates wound repair by supporting fibrin clot formation, promoting fibroblast proliferation, stimulating angiogenic signaling, and enabling re-epithelialization 31, 32. Together, these mechanisms highlight the therapeutic potential of probiotics in modulating cellular responses and enhancing tissue regeneration. This study aimed to evaluate the therapeutic potential of Bacillus clausii, Lactobacillus sporogenes, and Bifidobacterium longum strains not previously reported for diabetic wound healing. A PEG400/PEG4000/glycerol-based gel was formulated to preserve probiotic viability and support growth, with glycerol enhancing antioxidant stability. The formulation met key physicochemical parameters and maintained bacterial morphology and viability. Using a diabetic excision wound model, topical application of probiotic gels (F1, F2, F3) twice daily accelerated wound contraction compared to controls. By Day 14, histological analysis revealed complete re-epithelialization and collagen deposition in probiotic- and Placentrex-treated groups, while diabetic controls showed delayed healing. Translocation studies confirmed systemic presence of F1 and F3 strains, suggesting additional therapeutic effects via circulation.
CONCLUSION: The findings of this study present a compelling hypothesis supporting the therapeutic potential of probiotics in diabetic wound healing. Through the development and application of novel gel-based formulations containing Bacillus clausii, Lactobacillus sporogenes, and Bifidobacterium longum, a significant enhancement in wound recovery was observed in diabetic animal models compared to untreated controls. These results underscore the multifaceted benefits of topical probiotic therapy in overcoming the impaired healing typically associated with diabetic conditions. The probiotic treated groups demonstrated accelerated wound contraction, reduced inflammatory cell infiltration, enhanced collagen deposition, and improved re-epithelialization. These outcomes suggest that probiotics not only modulate the local immune response but also contribute to extracellular matrix remodelling and tissue regeneration. The gel formulation, optimized for bacterial viability and skin compatibility, further amplified these effects by maintaining a moist wound environment and supporting probiotic stability. Moreover, translocation studies indicated systemic circulation of certain probiotic strains, hinting at possible systemic immunomodulatory effects that may complement local wound healing. Taken together, these insights pave the way for future exploration into strain-specific mechanisms, formulation refinement, and clinical translation of probiotic-based therapies for chronic and diabetic wounds.
Future Perspective: Chronic and diabetic wounds continue to impose a substantial bioburden on global healthcare systems, exacerbated by rising antibiotic resistance, high treatment costs, and the risk of severe complications such as limb amputation. These limitations underscore the urgent need for alternative, cost-effective, and biologically compatible therapies. Topical probiotics have emerged as a promising frontier in wound care, owing to their ability to modulate the skin microbiota, enhance immune responses, and promote tissue regeneration. Their localized action offers distinct advantages over systemic therapies, including reduced side effects and targeted healing.
Among the strains investigated, Bacillus clausii shows considerable potential as an adjuvant therapy due to its robust antibacterial properties, immunomodulatory capacity, and regenerative influence on damaged tissue. Lactobacillus sporogenes, with its well-documented anti-inflammatory and tissue-repair-promoting effects, also stands out as a viable candidate for supportive wound care. Bifidobacterium longum, known for its role in reducing oxidative stress and regulating immune function, offers additional promise in managing diabetic wound pathology. To fully harness the therapeutic potential of topical probiotics, future research should focus on optimizing formulation parameters particularly those that preserve bacterial viability and enhance skin compatibility. Standardization of probiotic concentrations, stability profiling, and strain-specific efficacy studies will be critical for clinical translation. Additionally, exploring synergistic combinations of probiotics and postbiotics may unlock new dimensions in wound healing science. As the field advances, integrating microbiome-based therapies into mainstream dermatological and diabetic wound care protocols could revolutionize treatment outcomes and reduce the socioeconomic burden of chronic wounds.
Limitations: The current study presents several limitations that warrant consideration. Notably, animals treated with formulations F2 and F3 exhibited signs of infection, potentially linked to the systemic translocation of probiotic bacteria, as indicated by translocation assays. This raises concerns about the safety profile of certain probiotic strains when applied topically, particularly in immunocompromised or diabetic models. Furthermore, the study was primarily qualitative in nature, focusing on hypothesizing the potential role of probiotic bacteria in diabetic wound healing rather than establishing definitive therapeutic outcomes. Given the incomplete characterization of probiotic mechanisms specific to wound environments, especially under diabetic conditions, the findings should be interpreted as preliminary. A critical gap remains in the quantification of probiotic load within topical formulations. Accurate dosing, viability assessment, and strain-specific enumeration are essential for reproducibility and clinical translation. Future investigations should incorporate rigorous quantitative methodologies, including CFU counts, stability profiling, and dose-response analyses, to validate the therapeutic efficacy and safety of probiotic-based wound treatments.
ACKNOWLEDGEMENT: Authors are thankful to BVDU’s Poona College of Pharmacy, Pune for providing all the requirements and infrastructure facilities to carry out this research work.
Funding: This research did not receive any specific grant from funding agencies.
CONFLICT OF INTEREST: The authors declare no conflict of interest.
REFERENCES:
- Alberti KG and Zimmet PZ: Definition, diagnosis and classification of diabetes mellitus and its complications. Part 1: diagnosis and classification of diabetes mellitus provisional report of a WHO consultation. Diabet Med 1998; 15(7): 539-53.
- Gorecka J, Kostiuk V, Fereydooni A, Gonzalez L, Luo J, Dash B, Isaji T, Ono S, Liu S, Lee SR and Xu J: The potential and limitations of induced pluripotent stem cells to achieve wound healing. Stem Cell Research & Therapy 2019; 10(1): 87.
- Singh N, Armstrong DG and Lipsky BA: Preventing foot ulcers in patients with diabetes. Jama 2005; 293(2): 217-28.
- Driver VR, Fabbi M, Lavery LA and Gibbons G: The costs of diabetic foot: the economic case for the limb salvage team. Journal of the American Podiatric Medical Association 2010; 100(5): 335-41.
- Zhao R, Liang H, Clarke E, Jackson C and Xue M: Inflammation in chronic wounds. International Journal of Molecular Sciences 2016; 17(12): 2085.
- Leone S, Pascale R, Vitale M and Esposito S: Epidemiology of diabetic foot. Infez Med 2012; 20(1): 8-13.
- Harris-Tryon TA and Grice EA: Microbiota and maintenance of skin barrier function. Science 2022; 376(6596): 940-5.
- Marsh PD: The commensal microbiota and the development of human disease–an introduction. Journal of Oral Microbiology 2015; 7(1): 29128.
- Williams MR and Gallo RL: The role of the skin microbiome in atopic dermatitis. Current Allergy and Asthma Reports 2015; 15(11): 65.
- Puebla-Barragan S and Reid G: Forty-five-year evolution of probiotic therapy. Microbial Cell 2019; 6(4): 184.
- Maftei NM, Raileanu CR, Balta AA, Ambrose L, Boev M, Marin DB and Lisa EL: The potential impact of probiotics on human health: an update on their health-promoting properties. Microorganisms 2024; 12(2): 234.
- Hill C, Guarner F, Reid G, Gibson GR, Merenstein DJ, Pot B, Morelli L, Canani RB, Flint HJ, Salminen S and Calder PC: The international scientific association for probiotics and prebiotics consensus statement on the scope and appropriate use of the term probiotic. Nature reviews Gastroenterology & Hepatology 2014; 11(8): 506-14.
- Yin Z, Qiu Y, Han Y and Li K: Topical probiotics in wound care: a review of effects, mechanisms, and applications. Interdisciplinary Nursing Research 2024; 3(2): 63-71.
- Kadwaikar M and Shinde V: Healing with Microbial Allies: Exploration of Probiotics in Wound Management. Microbial Pathogenesis 2025; 107906.
- Urdaci MC, Bressollier P and Pinchuk I: Bacillus clausii probiotic strains: antimicrobial and immunomodulatory activities. J of Clinical Gastroenterology 2004; 38: 86-90.
- Schell MA, Karmirantzou M, Snel B, Vilanova D, Berger B, Pessi G, Zwahlen MC, Desiere F, Bork P, Delley M and Pridmore RD: The genome sequence of Bifidobacterium longum reflects its adaptation to the human gastrointestinal tract. Proceedings of the National Academy of Sciences 2002; 99(22): 14422-7.
- You J and Yaqoob P: Evidence of immunomodulatory effects of a novel probiotic, Bifidobacterium longum bv. infantis CCUG 52486. FEMS Immunology & Medical Microbiology 2012; 66(3): 353-62.
- Gagnon M, Savard P, Rivière A, LaPointe G and Roy D: Bioaccessible antioxidants in milk fermented by Bifidobacterium longum subsp. longum strains. BioMed Research International 2015; 2015(1): 169381.
- Babar V, Thomas R and Bhaskar M: Immunomodulatory activity of Lactobacillus sporogenes. IJTA 2012; 3: 32-8.
- Karimi F, Azadi A, Omidifar N, Najafabady NM, Mohammadi F, Kazemi R and Gholami A: Pharmacotechnical aspects of a stable probiotic formulation toward multidrug-resistance antibacterial activity: design and quality control. BMC Complementary Medicine and Therapies 2023; 23(1): 391.
- Verma P, Dutt R and Anwar S: Formulation and development of novel probiotic-loaded gel for the treatment of caffeine-induced anxiety. Journal of Applied Pharmaceutical Science 2023; 13(6): 121-7.
- Anushree U, Punj P, Vasumathi, Bharati S. Phosphorylated chitosan accelerates dermal wound healing in diabetic wistar rats. Glycoconjugate Journal 2023; 40(1): 19-31.
- Shinde V, Shende A and Mahadik K: Evaluation of antioxidant and wound healing potential of pomegranate peel gel formulation. Int J Pharmacogn 2020; 7(1): 23-8.
- Khan BA, Ullah S, Khan MK, Alshahrani SM and Braga VA: Formulation and evaluation of Ocimum basilicum-based emulgel for wound healing using animal model. Saudi Pharmaceutical Journal 2020; 28(12): 1842-50.
- Sharma G, Sharma M, Sood R, Neelamraju J, Lakshmi SG, Madempudi RS, Rishi P and Kaur IP: Self-preserving gelatin emulgel containing whole cell probiotic for topical use: Preclinical safety, efficacy, and germination studies. Expert Opinion on Drug Delivery 2021; 18(11): 1777-89.
- Salunke MR, Kala K, Mandlik DS, Ganeshpurkar A, Kulkarni R and Shinde V: Lycopene potentiates wound healing in streptozotocin-induced diabetic rats. Journal of Diabetes & Metabolic Disorders 2024; 23(1): 1359-70.
- De Almeida CV, Antiga E and Lulli M: Oral and topical probiotics and postbiotics in skincare and dermatological therapy: A concise review. Microorganisms 2023; 11(6): 1420.
- Azarang A, Farshad O, Ommati MM, Jamshidzadeh A, Heidari R, Abootalebi SN and Gholami A: Protective role of probiotic supplements in hepatic steatosis: a rat model study. BioMed Research International 2020; 2020(1): 5487659.
- Ommati MM, Li H, Jamshidzadeh A, Khoshghadam F, Retana-Márquez S, Lu Y, Farshad O, Nategh Ahmadi MH, Gholami A and Heidari R: The crucial role of oxidative stress in non-alcoholic fatty liver disease-induced male reproductive toxicity: the ameliorative effects of Iranian indigenous probiotics. Naunyn-Schmiedeberg's Archives of Pharmacology 2022; 395(2): 247-65.
- Bodas K and Shinde V: Healing of wounds: a detailed review on models, biomarkers, biochemical and other wound assessment parameters. Inflammation 2021; 9(3): 2069-85.
- Karimi F, Montazeri-Najafabady N, Mohammadi F, Azadi A, Koohpeyma F and Gholami A: A potential therapeutic strategy of an innovative probiotic formulation toward topical treatment of diabetic ulcer: an in-vivo study. Nutrition & Diabetes 2024; 14(1): 66.
- Salunke MR and Shinde V: Molecular insights and efficacy of guava leaf oil emulgel in managing non diabetic as well as diabetic wound healing by reducing inflammation and oxidative stress. Inflammopharmacology 2025; 33(3): 1491-503.
How to cite this article:
Agharkar A, Kelkar A, Tapadiya T, Mali G, Muthal A and Shinde V: Harnessing probiotics: gel-based therapies for diabetic wound healing. Int J Pharmacognosy 2025; 12(9): 740-51. doi link: http://dx.doi.org/10.13040/IJPSR.0975-8232.IJP.12(9).740-51.
This Journal licensed under a Creative Commons Attribution-Non-commercial-Share Alike 3.0 Unported License.
Article Information
6
740-751
1795 KB
456
English
IJP
Apurva Agharkar, Ankita Kelkar, Tushar Tapadiya, Gajanan Mali, Amol Muthal and Vaibhav Shinde *
Department of Pharmacognosy, Poona College of Pharmacy, Bharati Vidyapeeth (Deemed to be University), Pune, Maharashtra, India.
vaibhavshinde847@gmail.com
04 September 2025
25 September 2025
28 September 2025
10.13040/IJPSR.0975-8232.IJP.12(9).740-51
30 September 2025